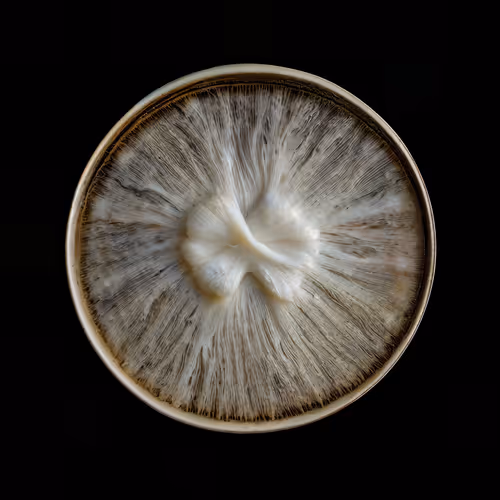
Item #16 Media

Precio máximo por artículoMáx. por artículo

mycelium network:abstraction
mycelium network:abstraction
Precio suelo
—
1d suelo %—
Oferta Top
—
Volumen 24h0,000,00 ETH
Volumen total0,000,00 ETH
anunciado0 %0 %
Propietarios (únicos)77 (35 %35 % )

mycelium network:abstractionmycelium network:abstraction
mycelium network:abstraction
mycelium network:abstraction